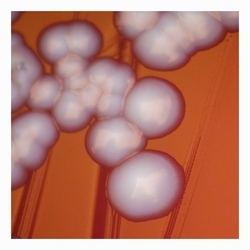
typical colony of E.coli without hemolysis
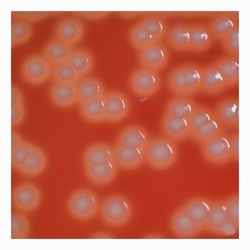
convex colonies with clear beta-hemolysis
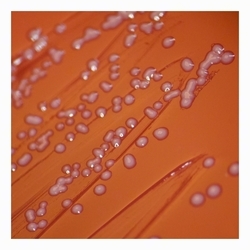
small-colony phenotype, nonhemolytic, nonpigmented colonies
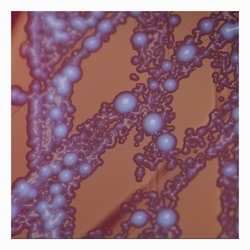
E.coli SCVs
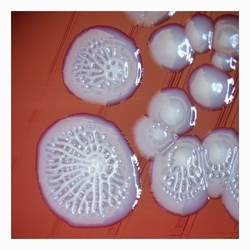
smooth to uneven colonies after prolonged cultivation¨, atypical colonies

The Many Faces of E. coli: Colony Morphology – 2026 Calendar
Escherichia coli — a Gram-negative, rod-shaped bacterium, typically about 2 µm long and 0.5 µm wide. Most motile strains possess 5–10peritrichous flagella, enabling movement in liquid environments. The cell surface is often covered with fimbriae, aiding adhesion to various
surfaces, including urinary tract epithelium. Worldwide, E. coli is the most common cause of urinary tract infections and is considered the
most frequent bacterial human pathogen, with an estimated ≈150 million UTI cases per year. The 12 isolates shown in this calendar
represent uropathogenic E. coli strains cultured on Columbia sheep blood agar; their identity was confirmed by MALDI-TOF MS.
Escherichia coli colony variants: twelve examples of how E. coli colonies can appear on blood agar.
|
|
 |
 |
| White-gray, smooth, convex colonies (4–5 mm) with entire margins; no hemolysis or medium discoloration (γ-hemolytic). |
Circular, convex colonies (4–5 mm) with clear β-hemolysis; about 30% of uropathogenic E. coli show this on blood agar. |
White, smooth, circular E. coli colonies (~4 mm) with a slight umbonate center; no hemolysis (γ-hemolysis). |
Gray, circular, umbilicate colonies (4–5 mm) with smooth surface and no hemolysis. |
 |
 |
|
|
| Irregular, raised gray colonies (4–10 mm) with rough surface and undulate to erose margins. |
Moist, irregular E. coli colonies (4–10 mm) with lobate margins. | Small-colony phenotype: tiny (1–2 mm), nonhemolytic, nonpigmented colonies with reduced growth. | SCVs form pinpoint, mostly nonpigmented colonies after 24–72 h; occasional larger colonies reach ~2 mm. |
 |
 |
 |
|
| Moist, mucoid colonies (~10 mm) typical of encapsulated uropathogenic E. coli. | Glistening, convex, pearly colonies (3–4 mm); hypermucoid strain with strong surface adherence. |
Heterogeneous colonies: flat, nonpigmented, uneven (up to 7 mm) and smooth, glossy white colonies. | Glistening, convex E. coli colonies, smooth to uneven (7 mm) after prolonged cultivation, 72 h at 37°C. |
Part of this calendar was released under a Creative Commons license and has been used as an illustration on the Wikipedia page dedicated to Escherichia coli.
